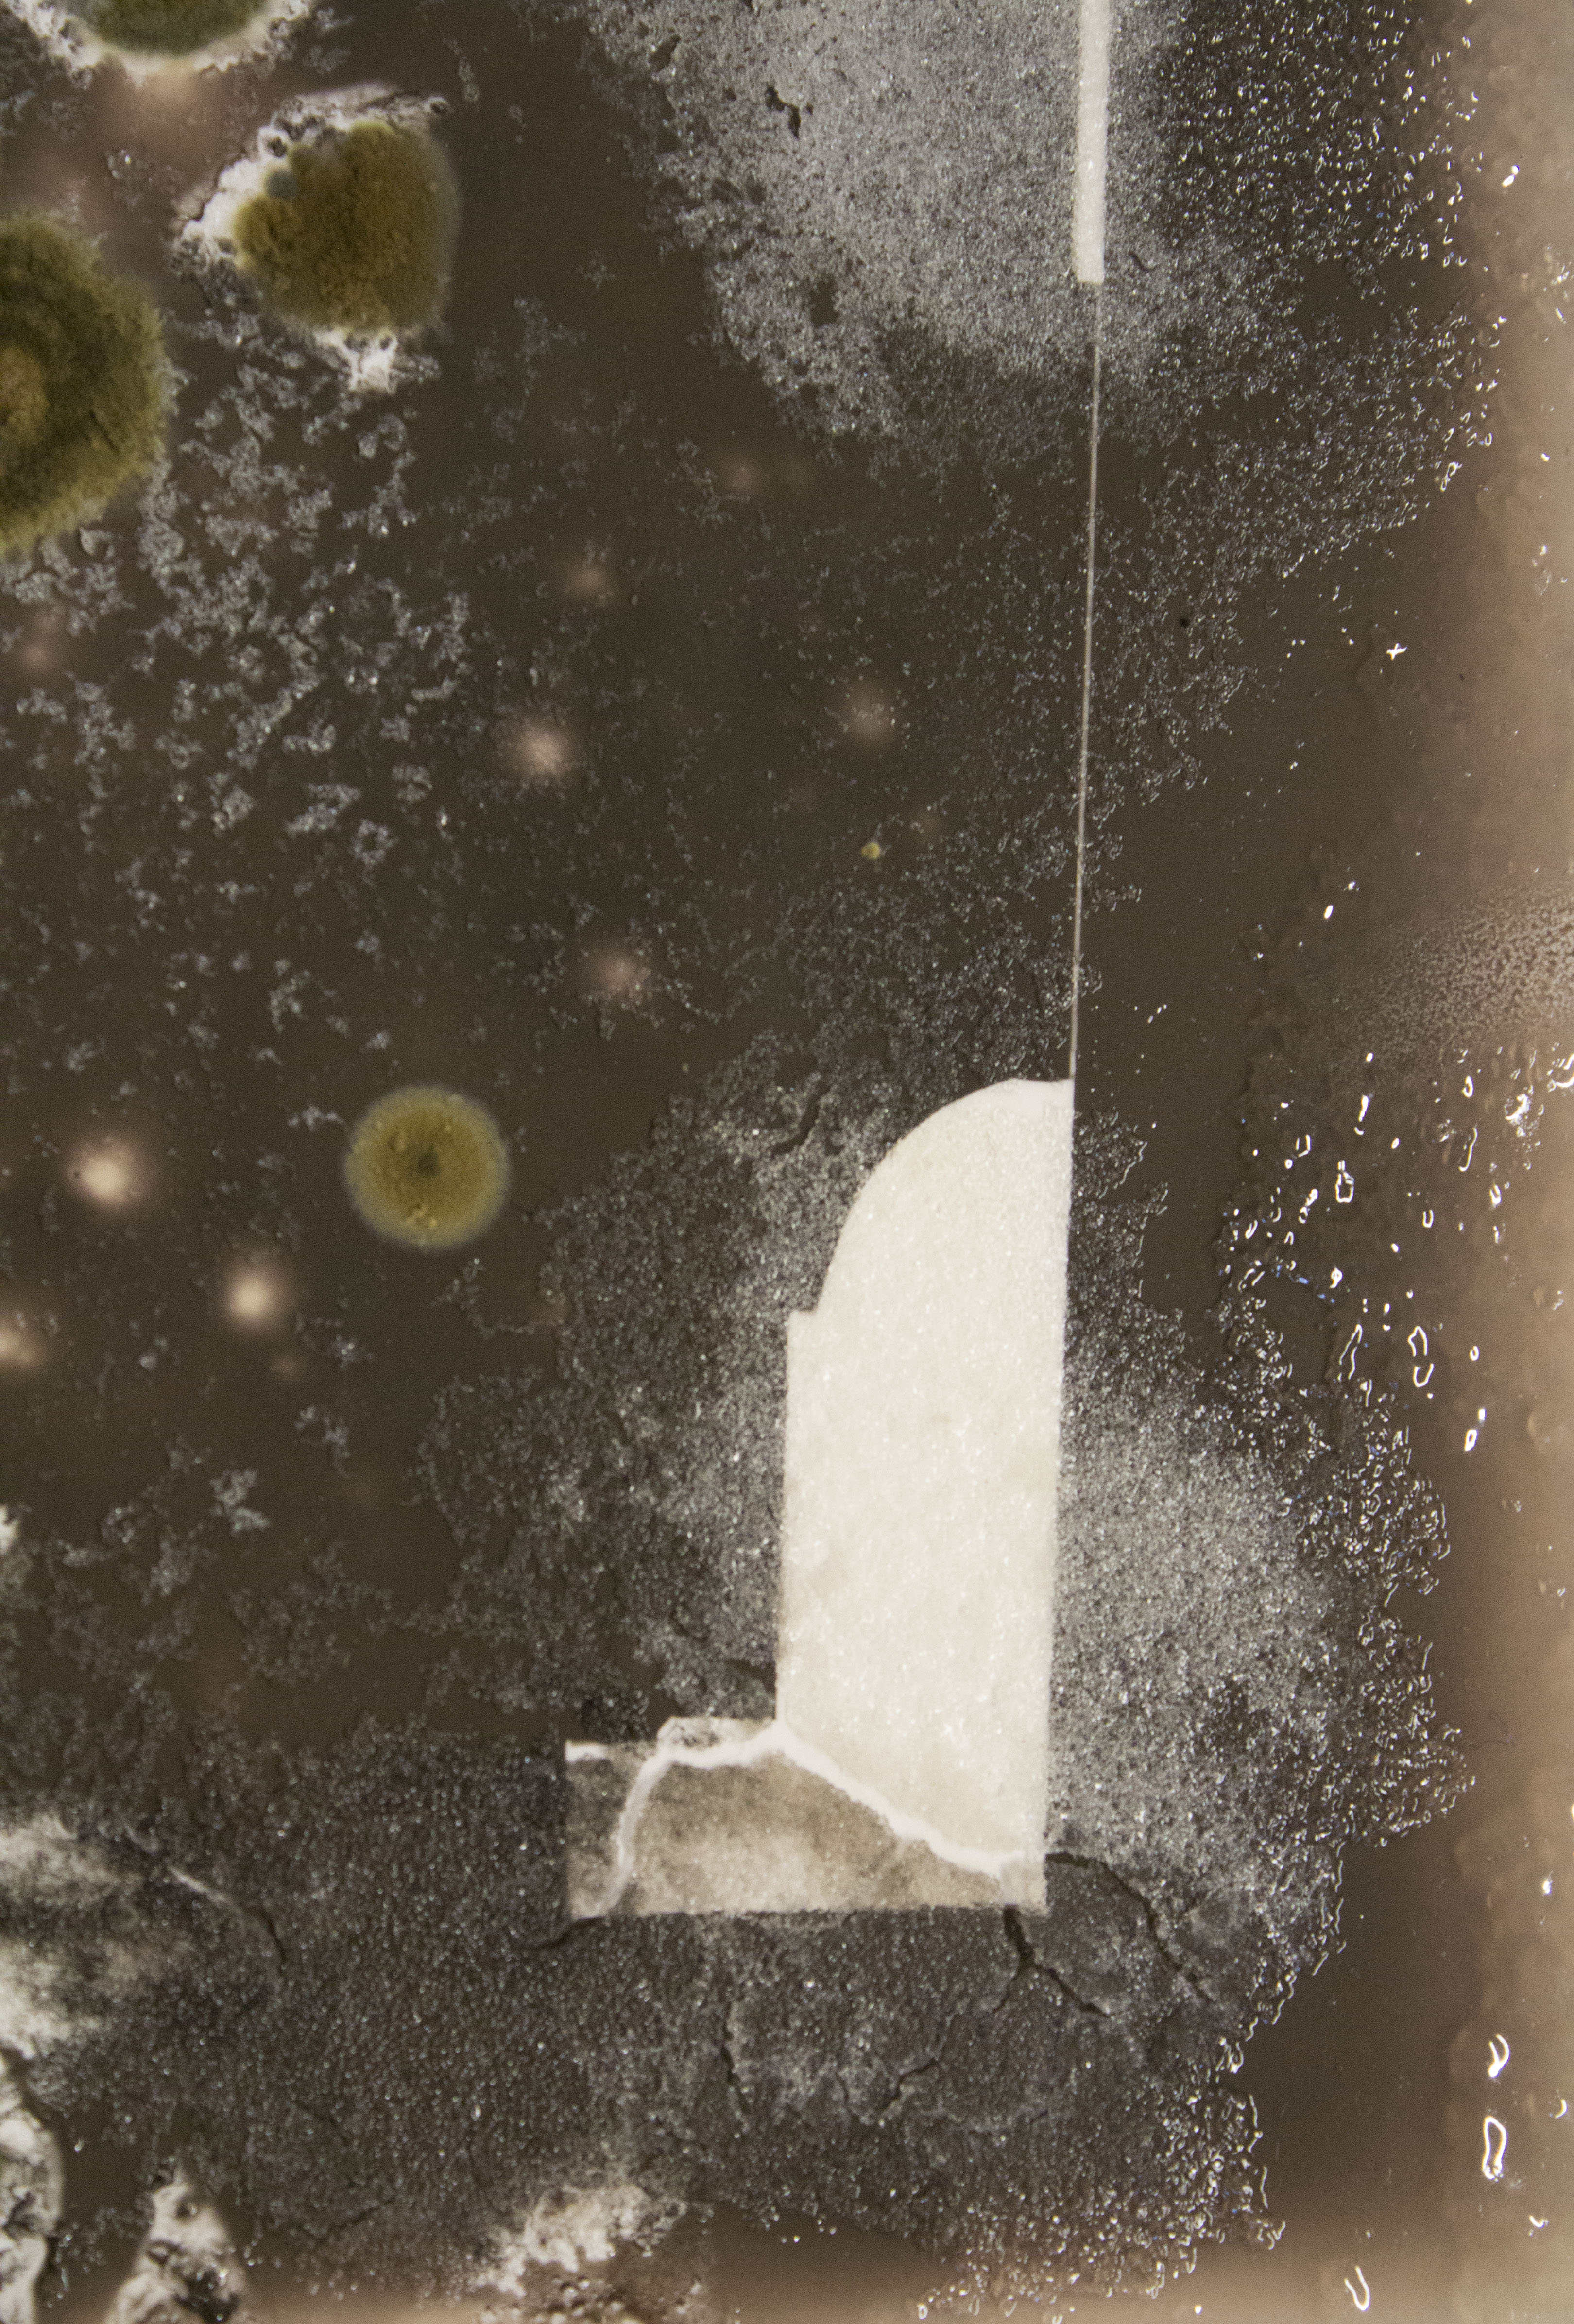

Architectual Healing, Cityscapes foundation 2018 Panopticon prison Haarlem
 |
|
 |
|||||||||
Architectual Healing, Cityscapes foundation 2018 Panopticon prison Haarlem |
|||||||||||
© 2019 Charlotte Koenen disclaimer contact: info@charlottekoenen.com